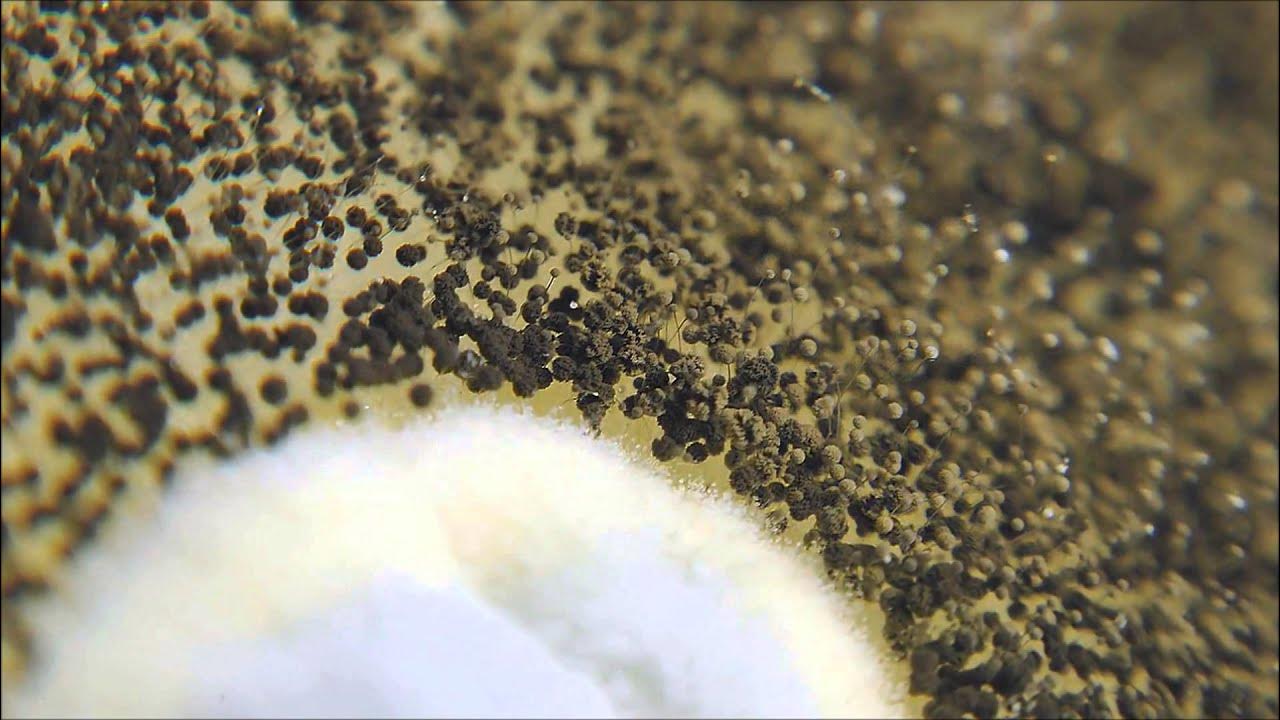
Augsne ir pārklāta ar pelējumu vai mušām: cēloņi un risinājumi.

Baltas plankumi uz augsnes podiņā un sīkas mušas podiņā ne tikai izskatās neestētiski, bet var būt arī kaitīgas veselībai. Šeit ir padomi, kā atbrīvoties no pelējuma un sēnīšu mušām.
Saturs
Jebkurš telpaugu īpašnieks zina šo problēmu: neskatoties uz pienācīgu kopšanu, uz augsnes pēkšņi parādās balts apsēsts. Dažreiz laistīšanas laikā pa to rāpo vai pulcējas sīkas mušas. Šādos gadījumos augu mīļotājiem jārīkojas ātri. Pelējums uz augsnes podā var būt kaitīgs veselībai. Arī sīkās mušiņas – parasti tās ir sēnīšu odiņas – nevajadzētu novērtēt par zemu. To kāpuri nopietni bojā augu saknes. Bet laba ziņa ir tā, ka ar mērķtiecīgu rīcību varat abas problēmas atrisināt uz visiem laikiem un saglabāt savu un savu augu veselību.
Vai tas patiešām ir pelējums?
Pirms veikt jebkādas darbības, ir jānosaka, vai baltais slānis ir pelējums. Reģionos ar ļoti cietu ūdeni tas var būt arī kaļķa nogulsnes. Tās var noskaloties augsnē, laistot.
Labākais veids, kā to pārbaudīt, ir uzmanīgi nokasīt balto nogulsni ar karoti vai koka nūjiņu. Ja tā ir cieta, drupina un viegli atdalās, visticamāk, tā ir kaļķa nogulsnes. Ja tā ir mīksta, varbūt tā ir pelējums.
Pelējums puķu podos – ko darīt?
Šādā gadījumā jums jārīkojas šādi:
Ir svarīgi pilnībā nomainīt augsni un izmest veco, sapelējušo. Tas ir nepieciešams, jo pelējums jau ir dziļi iesūcies augsnē, pirms tas kļūst redzams kā balts apvalks uz virsmas.
Mušu invāzija puķu podos – ko darīt?
Sēņu odiņas arī mīl mitru augsni podos, jo tā rada ideālus apstākļus to olu un kāpuru attīstībai. Tā ir problēma: kāpuri iekļūst saknēs, vājinot augu. Pirmais solis cīņā pret vieglu inficēšanos ir dzeltenu līmlapu izvietošana augsnē. Šīs līmlapas droši noķer lidojošos kukaiņus un neļauj pieaugušajiem īpatņiem dēt olas. Kvarca smilšu slānis uz augsnes virsmas arī novērš mazu melnu kukaiņu iekļūšanu augsnē un olu dēšanu.
Smagas inficēšanās gadījumā ir tikai viens risinājums: pilnīga augsnes nomaiņa.
Vai pelējums augsnē ir bīstams podos augošiem augiem?
Jā. Pelējums ir kaitīgs gan jūsu veselībai, gan augiem, tāpat kā pelējums uz sienām. Tāpēc jārīkojas pēc iespējas ātrāk.
Tāpēc lēta augsne podos augošiem augiem ātrāk sapelē.
Lēta, zemas kvalitātes augsnes maisījums ir īpaši pakļauts pelējuma veidošanās riskam. Tas saistīts ar tā sastāvu un sastāvdaļu kvalitāti. Lēta augsne parasti sastāv no komposta, melnās kūdras vai zemas kvalitātes koksnes šķiedras. Lai gan šie komponenti saglabā mitrumu un tādējādi teorētiski ir noderīgi augiem, tie arī ātri sadalās, radot ideālu vidi pelējuma vairošanās.
Turklāt augsnes sastāvdaļas sablīvējas, tiklīdz kļūst mitras. Gaisa dobumu trūkums nozīmē skābekļa trūkumu — vidi, kurā plaukst pelējums. Sakarā ar struktūras trūkumu un augsto mitruma uzglabāšanas spēju augsne ilgu laiku paliek mitra. Tā ir ideāla vide sēnīšu vairošanās. Dārgākas augsnes, no otras puses, satur drenāžas materiālus, kas novada lieko ūdeni un aerē augsni.
Vēl viens pieminēšanas vērts moments ir zemāki higiēnas standarti pie dažiem ražotājiem. Ja augsne ir jāražo pēc iespējas lētāk, svarīgi procesi, piemēram, organisko komponentu dezinfekcija, vienkārši tiek samazināti vai pilnībā izslēgti. Rezultātā pelējuma sporas un sēnīšu olas paliek augsnē un var izplatīties jūsu mājas puķu podos.
